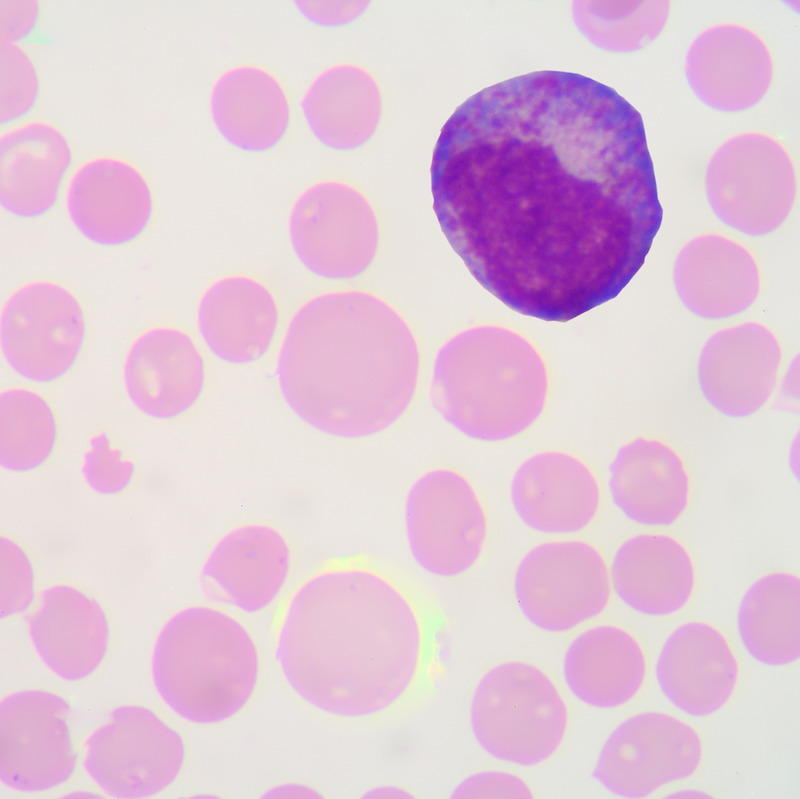
BioScans Online Personalized Nutrition & Supplement Test Sparrow

Sparrow Test Catalog
Sparrow Test Catalog - We are confident in the quality and craftsmanship of the Aura Smart Planter, and we stand behind our product. 72 Before printing, it is important to check the page setup options. This empathetic approach transforms the designer from a creator of things into an advocate for the user. Furthermore, the modern catalog is an aggressive competitor in the attention economy. Modern-Day Crochet: A Renaissance In recent years, the knitting community has become more inclusive and diverse, welcoming people of all backgrounds, genders, and identities. That catalog sample was not, for us, a list of things for sale. It’s the disciplined practice of setting aside your own assumptions and biases to understand the world from someone else’s perspective. I spent weeks sketching, refining, and digitizing, agonizing over every curve and point. 22 This shared visual reference provided by the chart facilitates collaborative problem-solving, allowing teams to pinpoint areas of inefficiency and collectively design a more streamlined future-state process. Teachers can find materials for every grade level and subject. It forces deliberation, encourages prioritization, and provides a tangible record of our journey that we can see, touch, and reflect upon. It's the difference between building a beautiful bridge in the middle of a forest and building a sturdy, accessible bridge right where people actually need to cross a river. It is a compressed summary of a global network of material, energy, labor, and intellect. The tactile nature of a printable chart also confers distinct cognitive benefits. Instead, they believed that designers could harness the power of the factory to create beautiful, functional, and affordable objects for everyone. 5 stars could have a devastating impact on sales. I imagined spending my days arranging beautiful fonts and picking out color palettes, and the end result would be something that people would just inherently recognize as "good design" because it looked cool. A blank canvas with no limitations isn't liberating; it's paralyzing. It is a testament to the fact that even in an age of infinite choice and algorithmic recommendation, the power of a strong, human-driven editorial vision is still immensely potent. Professional design is an act of service. People use these printables to manage their personal finances effectively. This forced me to think about practical applications I'd never considered, like a tiny favicon in a browser tab or embroidered on a polo shirt. And now, in the most advanced digital environments, the very idea of a fixed template is beginning to dissolve. It must be a high-resolution file to ensure that lines are sharp and text is crisp when printed. I discovered the work of Florence Nightingale, the famous nurse, who I had no idea was also a brilliant statistician and a data visualization pioneer. Sometimes you may need to use a wrench to hold the guide pin's nut while you turn the bolt. This brings us to the future, a future where the very concept of the online catalog is likely to transform once again. He argued that for too long, statistics had been focused on "confirmatory" analysis—using data to confirm or reject a pre-existing hypothesis. The typography is a clean, geometric sans-serif, like Helvetica or Univers, arranged with a precision that feels more like a scientific diagram than a sales tool. By the end of the semester, after weeks of meticulous labor, I held my finished design manual. You could sort all the shirts by price, from lowest to highest. In reaction to the often chaotic and overwhelming nature of the algorithmic catalog, a new kind of sample has emerged in the high-end and design-conscious corners of the digital world. It is the practical, logical solution to a problem created by our own rich and varied history. Don Norman’s classic book, "The Design of Everyday Things," was a complete game-changer for me in this regard. So don't be afraid to pick up a pencil, embrace the process of learning, and embark on your own artistic adventure. A well-designed chart communicates its message with clarity and precision, while a poorly designed one can create confusion and obscure insights. The use of proprietary screws, glued-in components, and a lack of available spare parts means that a single, minor failure can render an entire device useless. Facades with repeating geometric motifs can create visually striking exteriors while also providing practical benefits such as shading and ventilation. Our professor showed us the legendary NASA Graphics Standards Manual from 1975. It would shift the definition of value from a low initial price to a low total cost of ownership over time. Yet, when complexity mounts and the number of variables exceeds the grasp of our intuition, we require a more structured approach. This was a revelation. The catalog becomes a fluid, contextual, and multi-sensory service, a layer of information and possibility that is seamlessly integrated into our lives. A budget template in Excel can provide a pre-built grid with all the necessary categories for income and expenses, and it may even include pre-written formulas to automatically calculate totals and savings. This was a revelation. As mentioned, many of the most professionally designed printables require an email address for access. Vinyl erasers are excellent for precise erasing and cleaning up edges. The classic example is the nose of the Japanese bullet train, which was redesigned based on the shape of a kingfisher's beak to reduce sonic booms when exiting tunnels. Furthermore, drawing has therapeutic benefits, offering individuals a means of relaxation, stress relief, and self-expression. Unlike structured forms of drawing that adhere to specific rules or techniques, free drawing allows artists to unleash their creativity without constraints, embracing the freedom to experiment, improvise, and create without limitations. After reassembly and reconnection of the hydraulic lines, the system must be bled of air before restoring full operational pressure. Before you embark on your first drive, it is vital to correctly position yourself within the vehicle for maximum comfort, control, and safety. An honest cost catalog would have to account for these subtle but significant losses, the cost to the richness and diversity of human culture. Once you see it, you start seeing it everywhere—in news reports, in advertisements, in political campaign materials. The digital instrument cluster behind the steering wheel is a fully configurable high-resolution display. The democratization of design through online tools means that anyone, regardless of their artistic skill, can create a professional-quality, psychologically potent printable chart tailored perfectly to their needs. Software like PowerPoint or Google Slides offers a vast array of templates, each providing a cohesive visual theme with pre-designed layouts for title slides, bullet point slides, and image slides. A designer decides that this line should be straight and not curved, that this color should be warm and not cool, that this material should be smooth and not rough. This forced me to think about practical applications I'd never considered, like a tiny favicon in a browser tab or embroidered on a polo shirt. A satisfying "click" sound when a lid closes communicates that it is securely sealed. These platforms have taken the core concept of the professional design template and made it accessible to millions of people who have no formal design training. So, we are left to live with the price, the simple number in the familiar catalog. A pictogram where a taller icon is also made wider is another; our brains perceive the change in area, not just height, thus exaggerating the difference. This demonstrated that motion could be a powerful visual encoding variable in its own right, capable of revealing trends and telling stories in a uniquely compelling way. It is, perhaps, the most optimistic of all the catalog forms. The variety of available printables is truly staggering. It is a screenshot of my personal Amazon homepage, taken at a specific moment in time. Each chart builds on the last, constructing a narrative piece by piece. This is where things like brand style guides, design systems, and component libraries become critically important. The products it surfaces, the categories it highlights, the promotions it offers are all tailored to that individual user. Every action we take in the digital catalog—every click, every search, every "like," every moment we linger on an image—is meticulously tracked, logged, and analyzed. Indigenous art, for instance, often incorporates patterns that hold cultural and spiritual significance. I had to research their histories, their personalities, and their technical performance. This involves making a conscious choice in the ongoing debate between analog and digital tools, mastering the basic principles of good design, and knowing where to find the resources to bring your chart to life. It's a single source of truth that keeps the entire product experience coherent. Then there is the cost of manufacturing, the energy required to run the machines that spin the cotton into thread, that mill the timber into boards, that mould the plastic into its final form. I couldn't rely on my usual tricks—a cool photograph, an interesting font pairing, a complex color palette. In conclusion, the comparison chart, in all its varied forms, stands as a triumph of structured thinking. Living in an age of burgeoning trade, industry, and national debt, Playfair was frustrated by the inability of dense tables of economic data to convey meaning to a wider audience of policymakers and the public. It teaches us that we are not entirely self-made, that we are all shaped by forces and patterns laid down long before us.Download Reference Sheets for Sparrow ID
SPARROW TECH Test & Review (Is this reliable? Benefits, Cons, Score
Sparrow Catalogue PDF
Product Sparrow
Why You Should Know the Sparrow Case Raven Trust
Catalogue Sparrow 2025 Toutes les nouveautés au bout des doigts
GitHub cmgienger/8stress_test_sparrows practice for final exam
Tests Table of Contents Constitutional Law Fall 2023 Tests
Sparrow API Tool (sparrow_api) • Instagram photos and videos
Test Your Sparrow ID Skills Bird Academy • The Cornell Lab
KMi sparrow time test YouTube
Catalogs Sparrow & Sage
EarMen Sparrow Test du DAC USB indispensable Sitegeek.fr
Sparrow Catalogue PDF
GitHub skykks8544/SparrowTest TEST
Ventway Sparrow Learning Platform 12 Patient Circuit Test YouTube
Sparrow Lab Test Catalog Catalog Library
The Sparrow Test Raven Trust
Sparrow Hospital Test Catalog Catalog Library
Test Your Sparrow ID Skills Bird Academy • The Cornell Lab
BioScans Online Personalized Nutrition & Supplement Test Sparrow
Nominal Tests Erik Kusch
Sparrow Hospital Test Catalog Catalog Library
Ventway Sparrow Learning Platform 22 Circuit Verification Test CVT
Why You Should Know the Sparrow Case Raven Trust
Sparrow (test video with Nikon Z50 + FTZ II +Nikon 70300mm) YouTube
Sparrow Hospital Test Catalog Catalog Library
Test Your Sparrow ID Skills Bird Academy • The Cornell Lab
Sparrow Hospital Test Catalog Catalog Library
. Catalogue of Canadian birds [microform] part III, sparrows
Test Systems Sparrow MTS 30 Digitaltest GmbH
Test Flows Sparrow Documentation
A Guide to Sparrow Identification
New trial tests electrical stimulation for treatment retention in
Im Test Super Sparrow Trinkflasche Edelstahl 500ml Erfahrungen
Related Post:

![. Catalogue of Canadian birds [microform] part III, sparrows](https://c8.alamy.com/comp/REPJ7N/catalogue-of-canadian-birds-microform-part-iii-sparrows-swallows-vireos-warblers-wrens-titmice-and-thrushes-including-the-order-passeres-after-the-icterid-birds-oiseaux-image-evaluation-test-target-mt-s-4-a-icf-10-uamp-tin-m-us-ii-u-m-25-22-1-lllllio-118-l25-iu-iii1ii6-ix-p-gtm-w-7-photographic-sciences-corporation-23-west-main-svreet-web5terny-14580-716-872-4503-please-note-that-these-images-are-extracted-from-scanned-page-images-that-may-have-been-digitally-enhanced-for-readability-coloration-and-appearance-of-these-illustrations-m-REPJ7N.jpg)




